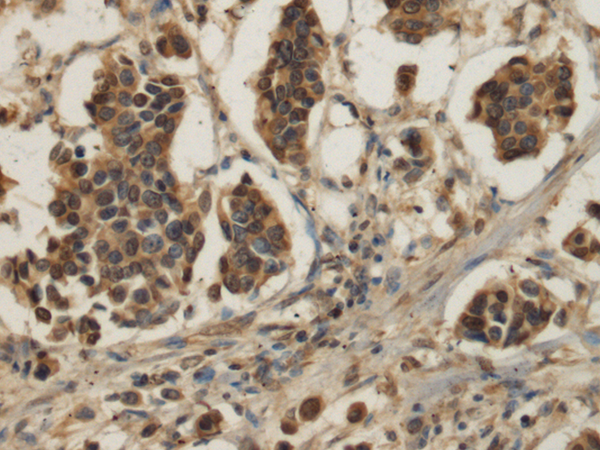
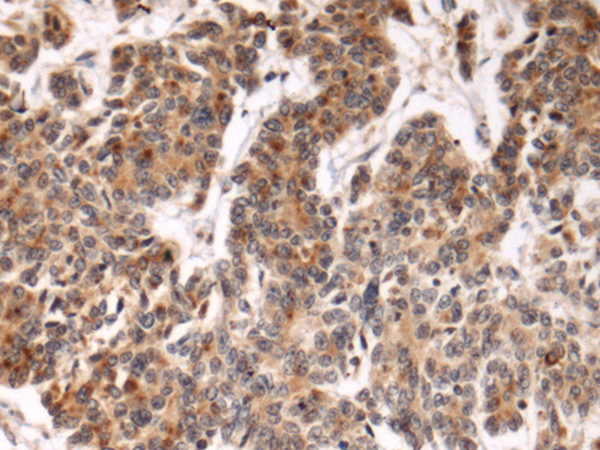
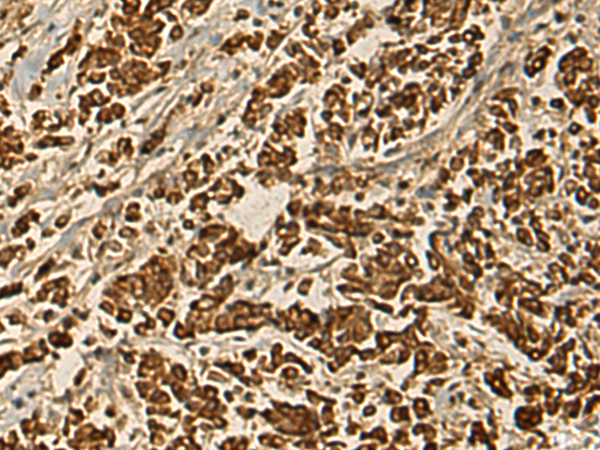

-
分类: 科研抗体货号: P10534别名: NER; UNR; LXRB; LXR-b; NER-I; RIP15应用: WB,IHC反应种属: Human, Mouse, Rat
-
分类: 科研抗体货号: P10518别名: TTLL5应用: WB,IHC反应种属: Human
-
分类: 科研抗体货号: P10532别名: KS; CEM1; KASI; FASN2D应用: WB,IHC反应种属: Human, Mouse
-
分类: 科研抗体货号: P10517别名: Fbl17; Fbx13; FBXO13应用: IHC反应种属: Human, Mouse
-
分类: 科研抗体货号: P10531别名: Fbx34; CGI-301应用: WB反应种属: Human, Mouse
-
分类: 科研抗体货号: P10516别名: ENGL; ENGLA; ENGLB; ENGL-a; ENGL-b; ENDOGL1; ENDOGL2应用: WB,IHC反应种属: Human, Mouse
-
分类: 科研抗体货号: P10530别名: IL-36R; IL1RRP2; IL-1Rrp2; IL1R-rp2应用: WB,IHC反应种属: Human
-
分类: 科研抗体货号: P10515别名: FBL3B; Fbl21; FBXL21; FBXL3B; FBXL3P应用: IHC反应种属: Human
-
分类: 科研抗体货号: P10529别名:应用: WB,IHC反应种属: Human, Mouse, Rat
-
分类: 科研抗体货号: P10514别名: MM46; ATG8A; GABARAP-a应用: WB,IHC反应种属: Human, Mouse, Rat

鄂公网安备42018502007531号
鄂公网安备42018502007531号

